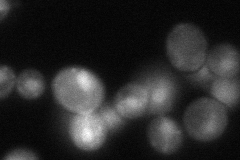
YMR072W

View description
Mitochondrial DNA-binding protein involved in mitochondrial DNA replication and recombination, member of HMG1 DNA-binding protein family; activity may be regulated by protein kinase A phosphorylation
Localization:
Intensity:
Fold change:
Significance:
-
C’ GFP library in SD

mitochondria162.34 -
N' NOP1pr-GFP in SD

mitochondria228.835 -
N' TEF2pr-mCherry in SD

mitochondria379.984 -
N' NATIVEpr-GFP in SD
punctate,nucleus70.3454 -
N' TEF2pr-VC and Cyto-VN in SD

#N/A0 -
C’ GFP library in SD+DTT

mitochondria145.670.89No -
C’ GFP library in SD+H2O2

mitochondria137.150.84No -
C’ GFP library in Starvation Media

mitochondria248.891.53Yes -
C’ GFP library on the background of Pup2-DaMP

mitochondria -
C’ GFP library on the background of CCT mutant

mitochondria120.8290.744254No
